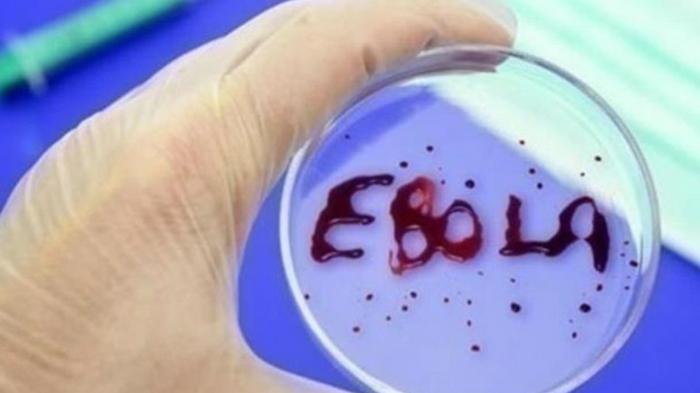

Бизнес
20.12.2019 в 23:34
530
Она назвала пять факторов снижения поступлений в бюджет.
|
 Статьи
20.12.2019 в 23:12
532
Для того чтобы зарегистрировать оффшорную компанию, следует предварительно определиться с подходящим названием.
|
 LifeStyle
20.12.2019 в 22:31
631
Сотрудники Федерального бюро расследований нашли мужчину, который был похищен из больницы лже-медсестрой 55 лет назад.
|
 Общество
20.12.2019 в 21:27
534
Количество официальных браков стало резко сокращаться с 2007 года. Тогда расписались вдвое больше пар, чем в 2019 году.
|
 LifeStyle
20.12.2019 в 20:43
789
Это исключительно редкое зрелище, говорит сотрудник заповедника Масаи-Мара
|
 IT
20.12.2019 в 19:45
670
Samsung не отказалась от складных телефонов и готовит Fold 2
|
 Общество
20.12.2019 в 18:40
694
В сети появилось видео как четверо юных "протестующих" против рынка земли под Радой по очереди курили самокрутку.
|
 Статьи
20.12.2019 в 18:07
705
Сейчас огромную популярность завоевала угловая модель дивана, ее присутствие позволяет зонировать пространство, разделяя комнату
|
 Политика
20.12.2019 в 17:17
591
Министр внутренних дел поручил полиции прекратить деятельность всех незаконных игорных заведений с 16:00.
|
Здоровье
20.12.2019 в 16:35
643
Вакцина Ervebo предназначена для предотвращения заболевания, вызванного вирусом Эбола, среди лиц от 18 лет и старше.
|
 Политика
20.12.2019 в 15:11
536
За неперсональное голосование вводится уголовная ответственность, а также штрафы до 85 тысяч гривен.
|
 Статьи
20.12.2019 в 14:48
858
Любая организация досуга или отдыха не только дисциплинирует, поможет более комфортно отдохнуть, но и позволит все спланировать заранее.
|
 Статьи
20.12.2019 в 14:39
1124
Как только квартира в Киеве была подписана на Панаитова, Вороненков был убит.
|
 Авто
20.12.2019 в 14:30
589
Рост бумаг Tesla отчасти вызван энтузиазмом в связи с началом производства электромобилей на новом заводе компании в Шанхае.
|
 Бизнес
20.12.2019 в 13:23
515
Индекс потребительских настроений опускается второй месяц подряд после рекорда в сентябре.
|
 Бизнес
20.12.2019 в 12:23
593
Украина во время переговоров намерена получить справедливую оплату за транспортировку газа, сообщил министр энергетики.
|
 Бизнес
20.12.2019 в 11:47
499
Нацбанк стабильно укрепляет гривну относительно доллара и евро. На межбанке гривна ускорила рост.
|
 Бизнес
20.12.2019 в 10:55
547
Новой монетой можно будет рассчитываться параллельно с банкнотами соответствующего номинала неограниченный период времени.
|
 Статьи
20.12.2019 в 10:21
836
Проектирование и монтаж водоснабжение частного дома не стоит выполнять самостоятельно, ведь в этом деле много важных тонкостей.
|
 Общество
20.12.2019 в 09:33
587
Пострадавший в ДТП пешеход будет возмещать водителю убытки из-за того, что судьи нашли на это четыре основания.
|
 Наука
20.12.2019 в 08:10
578
В ходе исследований выяснилось, что клетки, склонные к метастазированию, поглощают много молочной кислоты.
|
 Мир
20.12.2019 в 07:45
634
Средняя дневная температура по стране поднялась до 41,9°C. Предыдущий температурный рекорд был установлен всего сутками ранее.
|
 Мир
20.12.2019 в 06:50
580
Автомобиль пробил стену главного терминала аэропорта и врезался в стойку оформления проката автомобилей.
|
 Наука
20.12.2019 в 05:31
765
Ночной режим в современных смартфонах если не вреден, то как минимум бесполезен, считают эксперты, ссылаясь на проведенное исследование.
|
 Авто
20.12.2019 в 04:48
670
Volkswagen протестирует в столице Катара беспилотники ID Buzz
|
|